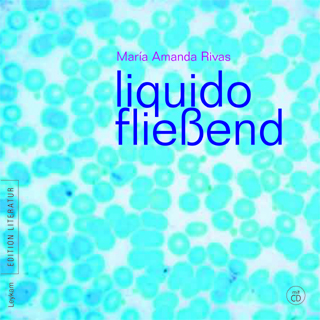

Eduardo Araica Trio & Berndt Luef Quartett
-
‹ Home
Contents
-
Categories
-
Tags
-
Archives
Links
- Afro-Asiatisches Institut Graz
- Casa de los Tres Mundos
- Fusión – Kulturkooperation Steiermark-Nicaragua
- Grupo Sal
- ifa-Online-Dossier “Kultur und Entwicklung”
- Jasmin & Josef @ Nicaragua
- Juan Eli Rodriguez
- Kultur Service Gesellschaft Steiermark
- Kulturen in Bewegung / VIDC
- Nicaragua Nachrichten
- NIcaúnidAT
- Paul Morales
- Projekt "asomate"
- Radio Fusión
- Radio Helsinki – Freies Radio Graz
- Radio Volcán – Das freie Radio für Granada
- Tina Reiter in Nicaragua
- Tipitapa en las Zonas Francas
- Österreichischer Auslandsdienst
-
RSS Feeds
-
Meta

Post a Comment